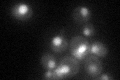
YLL022C

View description
Non-essential component of the HAT-B histone acetyltransferase complex (Hat1p-Hat2p-Hif1p), localized to the nucleus; has a role in telomeric silencing
Localization:
Intensity:
Fold change:
Significance:
-
C’ GFP library in SD
nucleus33.71 -
N' NOP1pr-GFP in SD

nucleus162.961 -
N' TEF2pr-mCherry in SD

nucleus19.6154 -
N' NATIVEpr-GFP in SD

punctate,nucleus23.275 -
N' TEF2pr-VC and Cyto-VN in SD

nucleus59.4977 -
C’ GFP library in SD+DTT

nucleus29.720.88No -
C’ GFP library in SD+H2O2

nucleus32.630.96No -
C’ GFP library in Starvation Media

nucleus47.081.39Yes -
C’ GFP library on the background of Pup2-DaMP

nucleus -
C’ GFP library on the background of CCT mutant

nucleus35.38661.04944No
